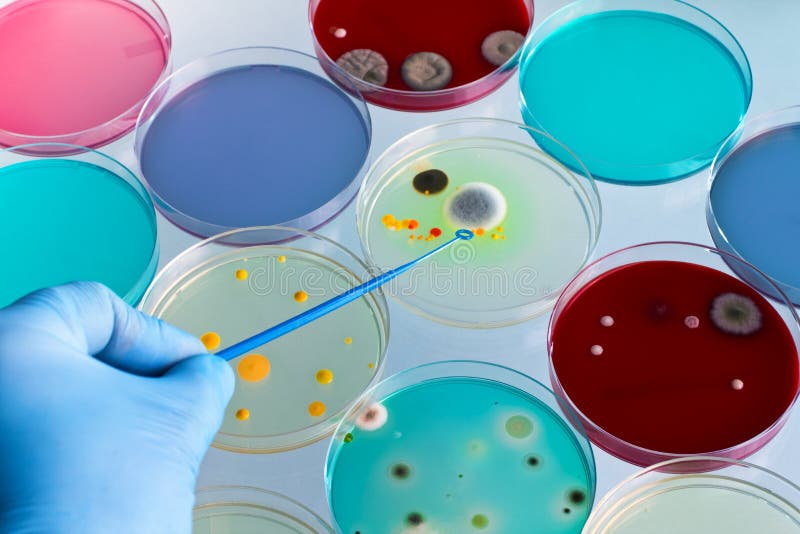

Значки и иконки чашки Петри: Символы науки



































































/imgs/2019/11/25/15/3670378/b1c0d0359a9466acb12754ac77099e9c3e9e957c.gif)

Раздел: Необычные решения